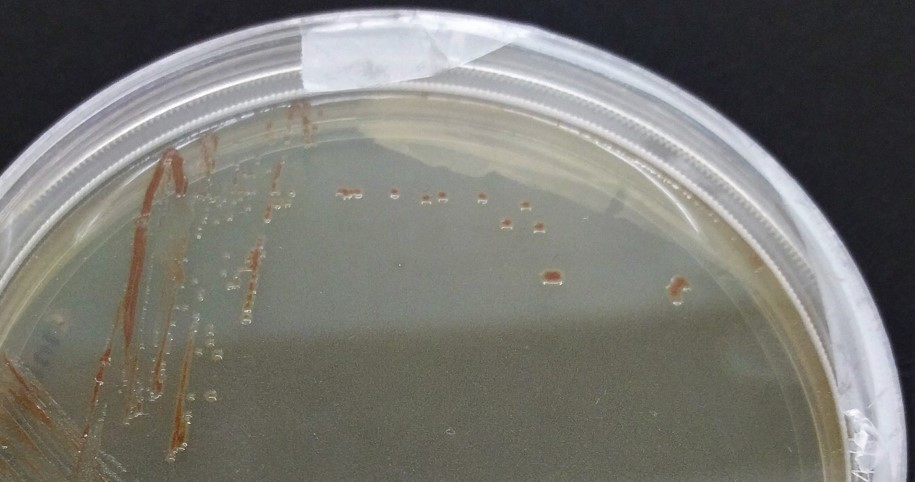
Woeseia oceani XK5 – the sole cultivated member of the Woeseiales bacteria – forming colonies on a solid culture medium. Photo: Alena di Primio, NIOZ

A real global player: Previously unrecognised bacteria may be a key group in marine sediments
Marine sediments cover more than two thirds of our planet’s surface. Nevertheless, they are scarcely explored, especially in the deeper regions of the oceans. For their nutrition, the bacteria in the deep ocean are almost entirely dependent on remnants of organisms that trickle down from the upper water layers. Depending on how they process this material, it either remains in the depths of the ocean for a long time or moves back to the surface as carbon dioxide. Thus, sea-floor bacteria play an important role in the global carbon cycle, which makes them an exciting and important research object.
Global players at the seafloor
The research team around Christina Bienhold and Katy Hoffmann from the Max Planck Institute in Bremen and Pierre Offre, who now works at the NIOZ on the island of Texel, has now identified and characterised a particularly dominant group of microbes. “Although these bacteria have been known in the literature for some time,” Bienhold explains, “nobody has paid much attention to them until now.” While the team focused on the role of this group in the deep sea, other researchers at the Max Planck Institute for Marine Microbiology investigated its importance in coastal sediments. “Only now does it become clear how numerous and widespread members of Woeseiales are,” Bienhold continues. An impressive 40 million cells inhabit each millilitre of deep-sea floor – together with a billion other bacteria. In a thimble full of sediment, there are thus about 120 million cells of Woeseiales. “We know of no other group of bacteria that occurs in the ocean floor at such high abundances.“ Extrapolated to the entire deep-sea floor, the worldwide population of Woeseiales would amount to 5 x 1026 cells, the authors estimate. “Considering that these estimates include neither the coastal sediments nor the deep biosphere, these bacteria may be one of the most common groups of microorganisms on Earth,” explains Bienhold.

A group with varied ecological roles
In their study, the authors present an ecological synthesis summarising current knowledge about the diversity and environmental distribution of these bacteria. The synthesis was built upon DNA sequence data, which were deposited in public databases over the last two decades, but also included new data, some of which was generated from arctic deep-sea sediments collected at the AWI-maintained long-term observatory HAUSGARTEN. “The analyses reveal that Woeseiales accommodate a myriad of organisms with varied ecologies,” explains Pierre Offre, lead author of the study. “For example, different species of Woeseiales co-exist together at any location of the seabed, where they probably fulfil different ecological functions. Our study provides a first ecological guide to these fascinating organisms.”
Moreover, the data now available indicate that members of Woeseiales could feed on so-called proteinaceous matter, such as the remains of cell walls and membranes or other leftovers of dead organisms. Considering that proteins are a major source of nitrogen – a fundamental nutrient for all life forms – in marine seafloor sediments, the potential ability of Woeseiales bacteria for protein degradation, may be ecologically important for the re-cycling of nitrogen in benthic ecosystems.“ I am convinced that further studies of these bacteria will provide new insights into the carbon and nitrogen cycles in marine sediments,” concludes Offre, who continues investigating these microorganisms to understand the secret of their ecological success, together with his research team at NIOZ.
The results presented here were obtained within the framework of the research project ABYSS headed by Antje Boetius, group leader at the Max Planck Institute for Marine Microbiology and director at the Alfred Wegener Institute Helmholtz Centre for Polar and Marine Research, which was funded by the European Research Commission between 2012 and 2018.
Further information on ABYSS can be found here: https://erc.europa.eu/projects-figures/stories/life-deep-microbes-abyss
Behind the paper: Read more about the work behind this publication in the corresponding blogpost by Christina Bienhold and Pierre Offre: https://naturemicrobiologycommunity.nature.com/users/348350-pierre-offre/posts/59450-spotlight-on-woeseiales-bacteria-cosmopolitan-denizens-of-marine-sediments

Article
Katy Hoffmann, Christina Bienhold, Pier Luigi Buttigieg, Katrin Knittel, Rafael Laso-Pérez, Josephine Z. Rapp, Antje Boetius, Pierre Offre (2020)
Diversity and metabolism of Woeseiales bacteria, global members of marine sediment communities, The ISME Journal https://dx.doi.org/10.1038/s41396-020-0588-4


